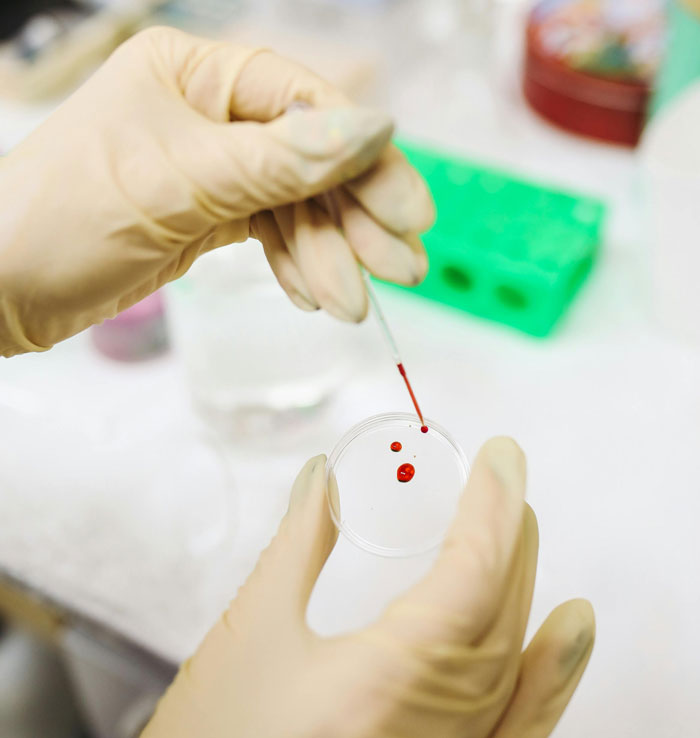
16 Científicos forenses cuentan cuál ha sido su descubrimiento más impactante

Hollywood suele retratar la ciencia forense bajo una luz fascinante. Es probable que mucha gente haya aspirado a trabajar en un laboratorio y analizar pruebas delicadas después de ver uno o dos episodios de CSI.
Pero una vez que se ha hecho el trabajo de verdad, la cosa cambia. Es probable que tengas respuestas dignas de mención a preguntas de Reddit como ésta: «¿Qué fue lo más impactante que se ha descubierto en tu laboratorio?».
Como de costumbre, los que han tenido experiencia de primera mano, o conocen a alguien que la haya tenido, dieron algunas de las respuestas más impactantes. Preparáos para leer historias sobre bebés que dieron positivo en sustancias ilegales, juguetes alojados en órganos internos y riñones con formas extrañas.
Disfruta leyendo estas respuestas, pero quizás no sea una buena idea comer mientras lo haces.
This post may include affiliate links.
 Que él ERA el padre.
Que él ERA el padre.
Llevo la facturación en una clínica y le hicimos la prueba a un bebé para ver si él era el padre.
La mamá y el papá eran rubios, la esposa tenía ojos azules, ambos parecían súper blancos.
El niño era REALMENTE negro. Le hicieron pruebas antes y no tenía ninguna enfermedad, sólo era negro.
El padre quería una prueba de paternidad porque cuando tienes dos padres blancos y un niño negro, surgen algunas preguntas.
Resulta que la madre tenía un abuelo negro que no aparecía en su piel y que ella desconocía.
El niño era biológicamente suyo, pero tenía un aspecto totalmente diferente.
El gen de la piel oscura no domina sobre el gen de la piel clara? No lo entiendo. Algún genetista que me lo explique?
 Tuve una profesora en la universidad que estaba haciendo su doctorado mientras trabajaba en la Clínica Mayo.
Tuve una profesora en la universidad que estaba haciendo su doctorado mientras trabajaba en la Clínica Mayo.
Año tras año, un hombre acudía para que le hicieran las pruebas de un trastorno/enfermedad que acabó con su padre en ese mismo hospital. Año tras año, daba negativo. Pero cada año se hacía las pruebas para adelantarse a la enfermedad. Porque, genética.
Un año dio negativo, como de costumbre, pero el personal tuvo una idea. Abrieron los archivos, sacaron el expediente de su padre y lo pusieron junto al suyo. El ADN no se parecía ni de cerca.
El pobre no tiene ni idea de que su difunto padre nunca fue su padre biológico. Y el hospital no tiene derecho ni obligación de informarle.
Ni el derecho ni la obligación, pero ir cobrando cada año por un seguimiento innecesario, eso si
 Asistí a una autopsia en la que el sujeto examinado tenía un riñón tan grande que se extendía a ambos lados del cuerpo en lugar de tener 2, uno a cada lado del cuerpo.
Asistí a una autopsia en la que el sujeto examinado tenía un riñón tan grande que se extendía a ambos lados del cuerpo en lugar de tener 2, uno a cada lado del cuerpo.
Y eso es bueno o malo? Le afectaba su salud? Alguien puede explicarme, por favor.
 En mi licenciatura en patología y antropología forense, hay un examen práctico final. El examinador trajo una gran caja de cartón. Del tipo en el que se guardan documentos.
En mi licenciatura en patología y antropología forense, hay un examen práctico final. El examinador trajo una gran caja de cartón. Del tipo en el que se guardan documentos.
Al volcarla sobre la mesa, parecía una maceta rota. Ningún trozo tenía más de 2,5 cm de diámetro. Entonces dice «¿podríais encontrar todos los trozos de este *ejemplo de hueso* y reconstruirlo, por favor?"
Resulta que era una chica de unos 16 años a la que su novio le había partido la cabeza con una piedra y cortado en trocitos antes de enterrarla en el campo.
La única razón por la que la encontraron fue porque su carne en descomposición hizo que las plantas que había justo al lado de su cuerpo fueran extrañamente grandes y frondosas para un campo seco y olvidado.
Aficionados y aficionadas a la horticultura, este no es un buen consejo para hacer prosperar mejor a vuestras plantas
 Acabo de empezar, así que lo que es impactante para mí es probablemente super menor, pero tuve un difunto que murió y fue encontrado con múltiples botellas de alcohol isopropílico a su alrededor con pajitas en ellos. Literalmente estaba sorbiendo alcohol isopropílico con pajitas. Obviamente eso acabó con ella, pero no puedo dejar de pensar en eso. ¿Cómo de grave es tu adicción para que hacer algo así tenga sentido? Sólo de pensarlo se me revuelve el estómago.
Acabo de empezar, así que lo que es impactante para mí es probablemente super menor, pero tuve un difunto que murió y fue encontrado con múltiples botellas de alcohol isopropílico a su alrededor con pajitas en ellos. Literalmente estaba sorbiendo alcohol isopropílico con pajitas. Obviamente eso acabó con ella, pero no puedo dejar de pensar en eso. ¿Cómo de grave es tu adicción para que hacer algo así tenga sentido? Sólo de pensarlo se me revuelve el estómago.
Tuve una pareja cuya madre era alcohólica. Como no podía tener alcohol en casa ni dinero, un día se bebió el limpiacristales y la tuvieron que ingresar de urgencia. Así de graves son las adicciones
 No es super impactante comparado con otros pero la primera vez que ves un ordenador cubierto de sangre lleno de agujeros de bala es un momento que no olvidas.
No es super impactante comparado con otros pero la primera vez que ves un ordenador cubierto de sangre lleno de agujeros de bala es un momento que no olvidas.
 La mujer de mi amigo trabaja en laboratorio. Al parecer, era bastante habitual recibir muestras de sangre de bebés que daban positivo en sustancias ilegales, pero el descubrimiento más reciente e impactante fue que las tuberías del edificio estaban hechas de tal manera que los productos químicos eliminados podían retroceder hasta el desagüe de la fuente de agua, y a la dirección no le importaba en absoluto.
La mujer de mi amigo trabaja en laboratorio. Al parecer, era bastante habitual recibir muestras de sangre de bebés que daban positivo en sustancias ilegales, pero el descubrimiento más reciente e impactante fue que las tuberías del edificio estaban hechas de tal manera que los productos químicos eliminados podían retroceder hasta el desagüe de la fuente de agua, y a la dirección no le importaba en absoluto.
 No soy científico, pero mi último trabajo consistió en realizar pruebas con equipos científicos y enviar los resultados al equipo jurídico de la empresa. Utilizando una pistola XRF descubrí que casi el 50% del inventario de esta gran empresa contenía cantidades de plomo superiores a las permitidas por la ley, además de otras sustancias químicas nocivas. (En una empresa cuyos productos la mayoría de la gente toca a diario). El equipo jurídico tenía mucho trabajo por delante.
No soy científico, pero mi último trabajo consistió en realizar pruebas con equipos científicos y enviar los resultados al equipo jurídico de la empresa. Utilizando una pistola XRF descubrí que casi el 50% del inventario de esta gran empresa contenía cantidades de plomo superiores a las permitidas por la ley, además de otras sustancias químicas nocivas. (En una empresa cuyos productos la mayoría de la gente toca a diario). El equipo jurídico tenía mucho trabajo por delante.
 Trabajaba como técnico de microscopía electrónica de barrido para la rama de I+D de una empresa privada cuando el científico jefe me dio una muestra desconocida para que la cortara e investigara. Tenía varias capas de pintura y quería saber qué elementos contenía. La mayoría de las capas mostraban elementos normales (Aluminio, cromo, etc), pero una de ellas tenía un pico de Pr (praseodimio), que es tan raro que olvidé que era un elemento. Pensé que me estaba volviendo loco, pero mi ingeniero volvió a comprobarlo y estaba claro que existía. Resulta que el praseodimio se utiliza en ciertas pinturas militares.
Trabajaba como técnico de microscopía electrónica de barrido para la rama de I+D de una empresa privada cuando el científico jefe me dio una muestra desconocida para que la cortara e investigara. Tenía varias capas de pintura y quería saber qué elementos contenía. La mayoría de las capas mostraban elementos normales (Aluminio, cromo, etc), pero una de ellas tenía un pico de Pr (praseodimio), que es tan raro que olvidé que era un elemento. Pensé que me estaba volviendo loco, pero mi ingeniero volvió a comprobarlo y estaba claro que existía. Resulta que el praseodimio se utiliza en ciertas pinturas militares.
Mi ex trabajaba en un laboratorio de genética.
Mi ex trabajaba en un laboratorio de genética.
No era raro recibir la mano de un recién nacido amputada para tomar muestras para pruebas genéticas en caso de aborto espontáneo o muertes prematuras.
 Hace años, cuando trabajaba como analista de ADN, nuestro laboratorio recibió una ensalada César de un restaurante local, con caja para llevar y todo. Al parecer, el tipo que pidió la ensalada dijo que se la habían servido con sangre. El dueño del restaurante dijo que no era posible y que el cliente debía haber sangrado en ella para no tener que pagar. El cliente decidió entonces llevar rápidamente su ensalada a nuestro laboratorio junto con su muestra de ADN para demostrar que no era suya. Resultó que sí lo era y que, sin saberlo, había sangrado en su ensalada.
Hace años, cuando trabajaba como analista de ADN, nuestro laboratorio recibió una ensalada César de un restaurante local, con caja para llevar y todo. Al parecer, el tipo que pidió la ensalada dijo que se la habían servido con sangre. El dueño del restaurante dijo que no era posible y que el cliente debía haber sangrado en ella para no tener que pagar. El cliente decidió entonces llevar rápidamente su ensalada a nuestro laboratorio junto con su muestra de ADN para demostrar que no era suya. Resultó que sí lo era y que, sin saberlo, había sangrado en su ensalada.
También hubo una vez en la que un padre envió al laboratorio un montón de productos de higiene femenina sucios de su hija para que los analizáramos en busca de semen.
 Riñón en forma de herradura. Se estaban haciendo varias autopsias a la vez y, cuando se descubrió, todos los médicos dejaron lo que estaban haciendo y se acercaron a mirar. Así que sospecho que las probabilidades son superiores a 1 entre 500.
Riñón en forma de herradura. Se estaban haciendo varias autopsias a la vez y, cuando se descubrió, todos los médicos dejaron lo que estaban haciendo y se acercaron a mirar. Así que sospecho que las probabilidades son superiores a 1 entre 500.
 La madre de una amiga mía trabajaba en la policía científica y nos contó un montón de historias, la más memorable fue cuando encontraron el cadáver de una chica descuartizado dentro de una bolsa de basura.
La madre de una amiga mía trabajaba en la policía científica y nos contó un montón de historias, la más memorable fue cuando encontraron el cadáver de una chica descuartizado dentro de una bolsa de basura.
Al principio pensaron que algún enfermo había acabado con ella y la había descuartizado, como hacen los enfermos. Pero tras investigar más a fondo, descubrieron algo en sus partes íntimas y un enorme agujero. Después de investigar un poco, descubrieron que se trataba de una uña acrílica.
Resulta que ella y su novia lo estaban haciendo cuando la uña de su novia se rompió y la rajó desde el interior y se desangró. La novia, en un momento de pánico, la descuartizó e intentó deshacerse del cuerpo.
 Estuve trabajando en un laboratorio durante un tiempo. Nada demasiado emocionante hasta que descubrimos que uno de nuestros compañeros de trabajo fue despedido por tener drogas, una pistola y otras cosas por el estilo en su oficina. Sé que no es exactamente lo que queríais en el hilo, pero fue con diferencia el descubrimiento más impactante.
Estuve trabajando en un laboratorio durante un tiempo. Nada demasiado emocionante hasta que descubrimos que uno de nuestros compañeros de trabajo fue despedido por tener drogas, una pistola y otras cosas por el estilo en su oficina. Sé que no es exactamente lo que queríais en el hilo, pero fue con diferencia el descubrimiento más impactante.
 Esta es una historia de mi abuelo. Mientras trabajaba en la policía científica tuvo que recoger un cuerpo encontrado en el fondo de un lago. Después de revisarlo aparentemente encontró que había un coche de Hot Wheels alojado en el pulmón izquierdo. Supuso que se lo habría tragado mientras estaba bajo el agua.
Esta es una historia de mi abuelo. Mientras trabajaba en la policía científica tuvo que recoger un cuerpo encontrado en el fondo de un lago. Después de revisarlo aparentemente encontró que había un coche de Hot Wheels alojado en el pulmón izquierdo. Supuso que se lo habría tragado mientras estaba bajo el agua.




